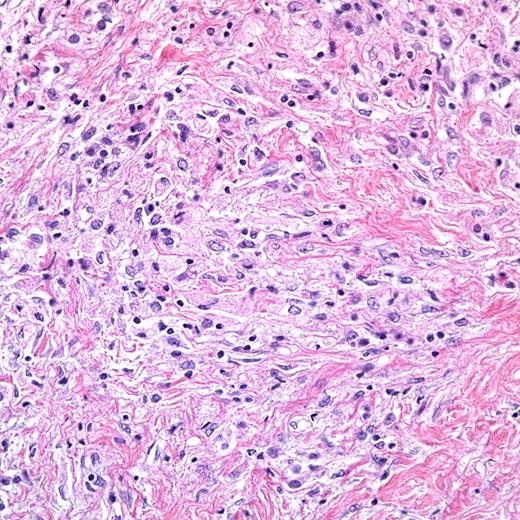
ECD lesion biopsy. (Image and interpretation courtesy of Dr Ronald Jaffe.)

Erdheim-Chester Disease (ECD) is an extraordinarily rare, poorly understood, and often fatal histiocytic disorder. In this issue of Blood, Arnaud and colleagues describe cytokine profiles in serum from patients with ECD and identify a systemic proinflammatory cytokine ECD-signature.1
EECD is a non-Langerhans histiocytosis first described by Chester as “lipoid granulomatose” in 1930.2 By 2010, only 350 additional cases had been added to the literature.3 Patients with ECD typically develop characteristic multifocal osteosclerotic lesions of long bones and may also develop extraskeletal histiocytic infiltrates of other sites including pituitary, orbit, retroperitoneum, kidneys, heart, lung, or central nervous system. Most patients with ECD die from their disease within 3 years of presentation.4
Histiocytic disorders have generally been divided into Langerhans cell histiocytosis (LCH) and non-Langerhans cell histiocytoses, with the assumption that LCH arises from pathologic epidermal Langerhans cells (LCs) and ECD and other non-Langerhans cell disorders arise from monocyte-macrophage lineage.5 ECD is defined by characteristic clinical presentation as well histology: Lesions are heterogeneous including inflammatory infiltrate along with foamy histiocytes with an immunophenotype distinct from LCH: CD68+, CD1a−, CD207−, S100−/low by immunohistochemistry, and Birbeck granules are absent (or rare) on electron microscopy.6 The figure demonstrates a representative hematoxylin/eosin-stained ECD lesion biopsy sample from a retroperitoneal, perinephric infiltrate (400× magnification). It shows the bland histiocytic infiltrate with foamy (xanthomatous) cytoplasm and interspersed inflammatory cells. Investigators have looked to the ECD lesions for clues to pathogenesis. Detailed immunohistochemical analysis of a small number of lesions found expression of many chemokines and chemokine receptors that direct lymphocyte and dendritic-cell activation and migration, suggesting the lesions may arise from immune dysregulation.7 Analysis of stimulated mononuclear cells from an ECD bone lesion from a single patient also demonstrated a proinflammatory microenvironment.8
ECD lesion biopsy. (Image and interpretation courtesy of Dr Ronald Jaffe.)
ECD lesion biopsy. (Image and interpretation courtesy of Dr Ronald Jaffe.)
Treatment strategies for ECD have been challenged by rare occurrence and poor understanding of etiopathology. Chemotherapy and corticosteroids effective in LCH and other histiocytic disorders appear to have minimal benefit.4 However, therapy with interferon-α (IFN-α) has been reported with durable responses in some patients.9,10 A rationale for this approach is that IFN-α induces terminal differentiation of some histiocytes and dendritic cells. Targeting interleukin-1 (IL-1), a proinflammatory cytokine expressed by ECD histiocytes, with recombinant interleukin-1 receptor-α (IL-1Rα) has also recently been reported as a promising therapeutic strategy.3
In this issue of Blood, Arnaud and colleagues quantitatively analyze 23 cytokines, chemokines, and growth factors in serum samples from 37 patients with ECD.1 They found many significant differences in cytokine/chemokine levels in ECD patients compared with controls, with principal component analysis identifying an ECD-specific signature based on increased expression of IFN-α, IL-12, monocyte chemotactic protein-1, and decreased expression of IL-4 and IL-7. Compared with controls, untreated patients had significantly elevated IL-6, and IFN-treated patients had significantly elevated IL-1Rα. There was no significant difference in cytokine profile comparing ECD patients treated with IFN-α to untreated patients. Furthermore, cytokine profiles were relatively unchanged over months in individual patients on whom serial plasma samples were available. The authors conclude that these data reveal ECD as a condition characterized by specific systemic proinflammatory activation that is not affected by treatment with IFN-α.
Previous studies demonstrated that histiocytes in ECD are clonal, consistent with a neoplastic process.11,12 However, the absence of Ki67+ cells suggests that they accumulate rather than proliferate within the lesions.7 In a single patient study, increased cytokine expression (IL-1α, IL-1β, IL-2, and IL-8) was noted in peripheral blood mononuclear subsets by quantitative polymerasechain reaction, demonstrating that cells other than the ECD histiocytes may contribute the proinflammatory plasma cytokine profile.13 The relative culpability of the ECD lesion histiocytes, peripheral blood dendritic cell precursors, circulating monocytes, or other cells in cytokine production, lesion formation, and disease progression remains to be determined. With this report, Arnaud et al's study supports a model in which the ECD cytokine microenvironment develops within a complex systemic inflammatory atmosphere. The ECD cytokine signature may provide further clues to pathogenesis as well as tools for diagnosis and targeted therapy.
Conflict-of-interest disclosure: The authors declare no competing financial interests. ■